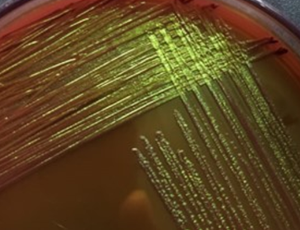

Loading

2025
Volume 3, Issue 1, p1-19
Articles published in this issue are Open Access and licensed under Creative Commons Attribution License (CC BY NC) where the readers can reuse, download, distribute the article in whole or part by mentioning proper credits to the authors.
Influence of milk containing water, penicillin and ammonium chloride on the processing properties and chemical composition of yoghurt and Sudanese white cheese
Tayseer, A. S. Idrees, Ibtisam, E. M. El Zubeir
Yoghurt and cheeses are important rich food for the human, however they might be subjected to adulteration, which alter their quality. This study investigated the effect of milk adulteration on the processing properties of yoghurt and Sudanese white cheese and their chemical composition. Cheese and yoghurt were made from milk with known amounts of added water, penicillin, and ammonium chloride; separately.
Arch Nutr Food Sci, 2025, Volume 3, Issue 1, p1-10 | DOI: 10.46439/nutrition.3.008
Bacteriological assessment of fresh Grewia asiatica juice from street vendors in urban Pakistan
Syeda Noor Fatima, Shaherbano, Fariha Arif , Iram Shahzadi
Street vended fruit juices are widely consumed in Pakistan, particularly during extreme summer heat, providing essential nutrition values mostly fulfilled by fruits and their juices. Generally, microbial growth in juice is restricted by using preservatives and storage temperatures. From public health point of view, presence of microbes can cause foodborne diseases and outbreaks.
Arch Nutr Food Sci, 2025, Volume 3, Issue 1, p11-19 | DOI: 10.46439/nutrition.3.009
Recommended Articles
Understanding microbial influence on mental health
The past decade in science has seen an influx of new research articles showing the relationship between the human gut microbiome and its direct or indirect effect on the Central Nervous System (CNS). Much of the current research points to microbial therapy as a potential treatment option for many mental health disorders and conditions.
Dietary practice among mainstream bengali population and ethnic communities in bangladesh
Bangladesh has a number of ethnic minor group population and they lead their life in great ethnic diverse fashion [1]. They constitute about 1% of total population [1]. They are distributed in scattered way all over the hilly, riverine and dense forest region of the country [1].
Glucan and Vitamin D supplementation showed synergy in improvements of the immune response against an influenza challenge in mice
Influenza infection remains a serious health problem throughout the world. Unfortunately, current medicine offers no real treatment or protection, moving our attention to alternative options. In this study we aimed to evaluate the possible effects of a combination of glucan and vitamin C on immunosuppression caused by influenza infection.
Food-to-mealtime associations influence food selection in a UK-based sample
Humans tend to consume food throughout the day in a regular pattern [1]. This routinised behaviour reflects primal foraging strategies of repeating tried and tested fruitful paths to obtain food, without predation or starvation [2]. Modern-day food-related routines are still unpinned by these ancestral behaviours but are shaped by social, environmental and culture factors that influence preferences and beliefs about food [3,4].
Current understanding of gender dimorphism regarding type 2 diabetes
Today, both type 1 and type 2 diabetes mellitus affect 33.3 million people in the United States and nearly 500 million adults worldwide, and there is concern that this number may increase steadily in the future. Previous studies have linked the development of type 2 diabetes to multiple lifestyle factors, including physical activity level and diet, and biological characteristics, such as body composition, age, and race; however, current research suggests that gender may also have an impact on one’s risk of developing type 2 diabetes. Variations in type 2 diabetes diagnosis, prevalence, and progression have been found between males and females.
High exposure to pollution requires nutritional improvements in children
Sickness rates of children living in regions with extreme environmental pollution resulted in our study evaluating effects of 30-day supplementation with two different food supplements containing nucleotides, amino acids and polypeptides or β-glucan. This study was based on published studies evaluating these effects on children with chronic respiratory problems transported to the region without environmental pollution and into the medical program complemented with climatotherapy, speleotherapy, higher motion activity, rehabilitation, and a special nutritional program.
Further comments on the single-cell protein ingredient manufactured from a non-GMO Corynebacterium glutamicum as an alternative protein nutrition
In the previous study, Park et al. reported the efficacy of a single-cell protein manufactured from a growth-accelerated high-vital Corynebacterium glutamicum strain and potential strain selection strategy for development of non-GMO industrial strains harboring enriched target nutritional component, named as growth?acceleration?targeted evolution (G.A.T.E.) strategy [1].
Influence of milk containing water, penicillin and ammonium chloride on the processing properties and chemical composition of yoghurt and Sudanese white cheese
Yoghurt and cheeses are important rich food for the human, however they might be subjected to adulteration, which alter their quality. This study investigated the effect of milk adulteration on the processing properties of yoghurt and Sudanese white cheese and their chemical composition. Cheese and yoghurt were made from milk with known amounts of added water, penicillin, and ammonium chloride; separately.
Bacteriological assessment of fresh Grewia asiatica juice from street vendors in urban Pakistan
Street vended fruit juices are widely consumed in Pakistan, particularly during extreme summer heat, providing essential nutrition values mostly fulfilled by fruits and their juices. Generally, microbial growth in juice is restricted by using preservatives and storage temperatures. From public health point of view, presence of microbes can cause foodborne diseases and outbreaks.
